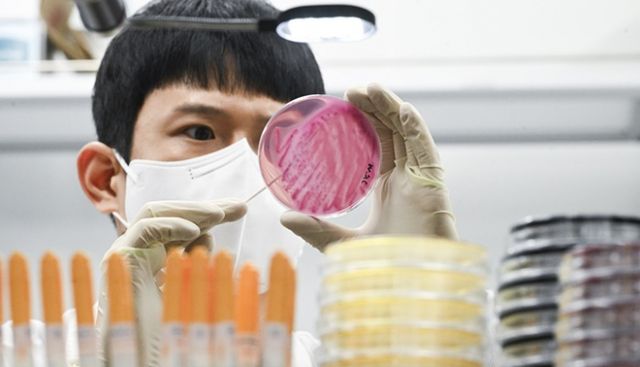
식중독 증상을 보인 육군 17사단 병사들이 섭취한 배추김치에서 노로바이러스균이 검출됐다. 사진은 지난 9월29일 경기 수원시 권선구 경기도보건환경연구원에서 감염병연구부 수인성질환팀 직원이 식중독균 배양검사를 하는 모습. 해당 기사와 상관없음. /사진=뉴스1

식중독 증상을 보인 육군 17사단 병사들이 섭취한 배추김치에서 노로바이러스균이 검출됐다. 사진은 지난 9월29일 경기 수원시 권선구 경기도보건환경연구원에서 감염병연구부 수인성질환팀 직원이 식중독균 배양검사를 하는 모습. 해당 기사와 상관없음. /사진=뉴스1
식중독 증상을 보인 육군 17사단 병사들이 섭취한 배추김치에서 노로바이러스균이 검출됐다. 사진은 지난 9월29일 경기 수원시 권선구 경기도보건환경연구원에서 감염병연구부 수인성질환팀 직원이 식중독균 배양검사를 하는 모습. 해당 기사와 상관없음. /사진=뉴스1
27일 뉴스1에 따르면 인천시 보건환경연구원은 이날 육군 17사단 병사들이 섭취한 배추김치에서 노로바이러스가 검출됐다고 밝혔다.
육군 17사단에 따르면 지난달 26일부터 28일까지 인천 연수구(1곳·3명), 서구(1곳·5명), 부평구(11곳, 53명), 계양구(1곳·1명), 김포시(1곳·4명)에 주둔 중인 예하 부대 소속 병사 등이 설사와 고열 등 식중독 증상을 호소했다.
군부대로부터 병사 52명의 검체를 받은 시 보건당국은 이들의 검체를 조사한 결과 19명에게 식중독균을 발견했다.
노로바이러스는 겨울에 흔히 발생하는 식중독의 원인 바이러스이다. 급성위장염을 일으키고 전염력이 강하다. 노로바이러스에 감염되면 1~2일의 잠복기를 거치고 이후 구토나 설사, 발열, 복통 등의 증상이 나타난다.
이에 군 당국은 배추김치를 납품한 식자재 업체와 계약을 해지했다.
Copyright ⓒ 머니S 무단 전재 및 재배포 금지
본 콘텐츠는 뉴스픽 파트너스에서 공유된 콘텐츠입니다.



